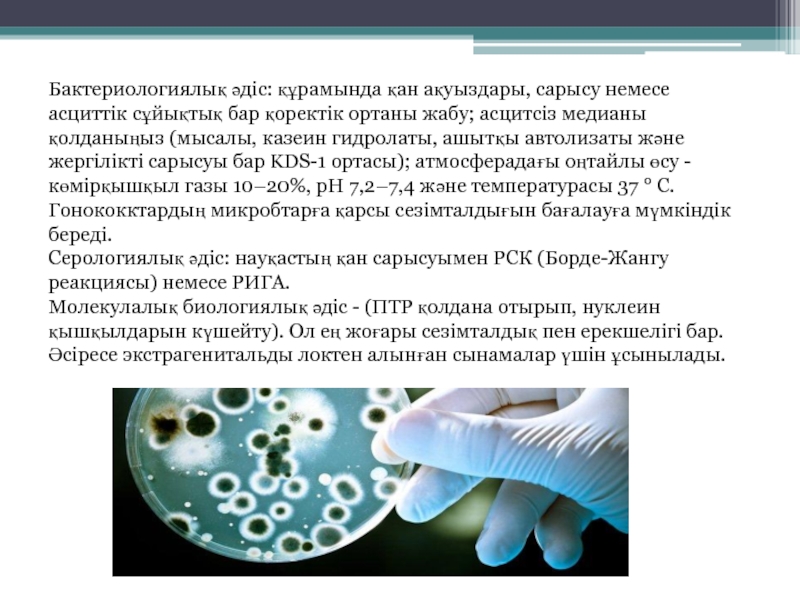

Разделы презентаций
- Разное
- Английский язык
- Астрономия
- Алгебра
- Биология
- География
- Геометрия
- Детские презентации
- Информатика
- История
- Литература
- Математика
- Медицина
- Менеджмент
- Музыка
- МХК
- Немецкий язык
- ОБЖ
- Обществознание
- Окружающий мир
- Педагогика
- Русский язык
- Технология
- Физика
- Философия
- Химия
- Шаблоны, картинки для презентаций
- Экология
- Экономика
- Юриспруденция
Гонорея
Содержание
- 1. Гонорея
- 2. Гонорея (Соз)Соз (лат. Gonorrhoea) — ең зиянды жұқпалы жыныс ауруларының бірі, жіңішке деп те
- 3. Соз тұқым қуаламайды, алайда, босанатын әйел соз
- 4. Жұғу механизміЕресек адамдарға ауру жыныстық қатынас кезінде,
- 5. Клиникасы ЕрлердеЖасырын кезеңі бір күннен 2 —
- 6. ӘйелдердеӘйелдер С-ға шалдыққанда, гонококк алдымен жатыр мойнының шырышты
- 7. ДиагностикаМикробиологиялық диагностика.Бактериоскопиялық (микроскопиялық) әдіс - екі бояуды
- 8. Бактериологиялық әдіс: құрамында қан ақуыздары, сарысу немесе
- 9. ЕміАнтибиотиктерСульфаниламидтерИммунотерапия Физиотерапия
- 10. ПрофилактикаЖеке бастың гигиенасын сақтауМүше қаппен қолдану
- 11. Ауырмай аман сау болыныздар!!!
- 12. Скачать презентанцию
Гонорея (Соз)Соз (лат. Gonorrhoea) — ең зиянды жұқпалы жыныс ауруларының бірі, жіңішке деп те атайды.СОЗ, гонорея (gonorrhoea) — жыныстық қатынас арқылы жұғатын жұқпалы ауру. Создың қоздырғышы — Neіsserіe тобына жататын гонококк. Оны 1879 ж. неміс дерматолог-венерологы А.Нейссер (1855 —
Слайды и текст этой презентации
Слайд 2Гонорея (Соз)
Соз (лат. Gonorrhoea) — ең зиянды жұқпалы жыныс ауруларының бірі, жіңішке деп те атайды.
СОЗ, гонорея (gonorrhoea)
Слайд 3Соз тұқым қуаламайды, алайда, босанатын әйел соз ауруы болса, оны
өз баласына жұқтыруы мүмкін.
Гонококк - бұл іштегі ішіне қарай бүктелген
кофе дәндеріне ұқсас бактериялар жұбы. Инфекцияның негізгі жолы - жыныстық. Жұқтырған серіктеспен бір жыныстық байланыста болғаннан кейін де гонореямен ауыру мүмкіндігі 60-90% жетедіСлайд 4Жұғу механизмі
Ересек адамдарға ауру жыныстық қатынас кезінде, ал балаларға дерт ата-анасынан (мыс.,
босану кезінде)
Кейде дерт науқас адаммен бір төсекте жатса, оның сүлгісін, ыдыс-аяғын
пайдалансаСлайд 5Клиникасы
Ерлерде
Жасырын кезеңі бір күннен 2 — 3 аптаға дейін созылуы
мүмкін.
Ауру еркектерде үрпіден, әйелдерде жатыр мойнынан басталады. Ер адам
Соз ауруына шалдыққанда, гонококк ағзаға өткеннен кейін қабыну процесі жүреді. Науқастың денесі күйіп, қышына бастайды, кіші дәретке отырғанда ауырсынады. 1 — 2 күннен кейін несепке іріңді зат араласып, кіші дәретке отырғанда қуық қатты ашып ауырып, үрпі қызарып, ісінеді. Бұл кезде науқастың дене қызуы көтерілуі мүмкін, әлсіздік пайда болып, тамаққа зауқы соқпайдыСлайд 6Әйелдерде
Әйелдер С-ға шалдыққанда,
гонококк алдымен жатыр мойнының шырышты
қабығын қабындырады.
Әйелдерде ауру белгісі бірден білінбейді,сондықтан дерт асқынып кетеді. Бұл кезде
жатыр мойны іріңге толып, әйелдің белі және іші төмен тартып, қатты ауырады. Ауру әбден асқынғанда, кіші дәретке отыру қиындап, несепке қан араласады. Созбен ауырғанда дұрыс ем қабылдап, толық жазылып кетпесе, еркек те, әйел де бедеулікке шалдығады.Слайд 7Диагностика
Микробиологиялық диагностика.
Бактериоскопиялық (микроскопиялық) әдіс - екі бояуды бояу:
1)Граммен
2)Метилен көк
1% сулы ерітіндісі және 1% спирт ерітіндісі.
Әдістің жоғары сезімталдық пен
ерекшелігі бар (90-100%), тек айқын көрінісі бар еркектердегі уретралды разрядты зерттегенде. Микроскопия әдісі жатыр мойны, фарингеальды және тік ішек сынамаларын, сондай-ақ асимптоматикалық инфекцияларды зерттеуде төмен сезімталдықпен сипатталады (45-64%).Слайд 8Бактериологиялық әдіс: құрамында қан ақуыздары, сарысу немесе асциттік сұйықтық бар
қоректік ортаны жабу; асцитсіз медианы қолданыңыз (мысалы, казеин гидролаты, ашытқы
автолизаты және жергілікті сарысуы бар KDS-1 ортасы); атмосферадағы оңтайлы өсу - көмірқышқыл газы 10–20%, рН 7,2–7,4 және температурасы 37 ° C. Гонококктардың микробтарға қарсы сезімталдығын бағалауға мүмкіндік береді.Серологиялық әдіс: науқастың қан сарысуымен РСК (Борде-Жангу реакциясы) немесе РИГА.
Молекулалық биологиялық әдіс - (ПТР қолдана отырып, нуклеин қышқылдарын күшейту). Ол ең жоғары сезімталдық пен ерекшелігі бар. Әсіресе экстрагенитальды локтен алынған сынамалар үшін ұсынылады.